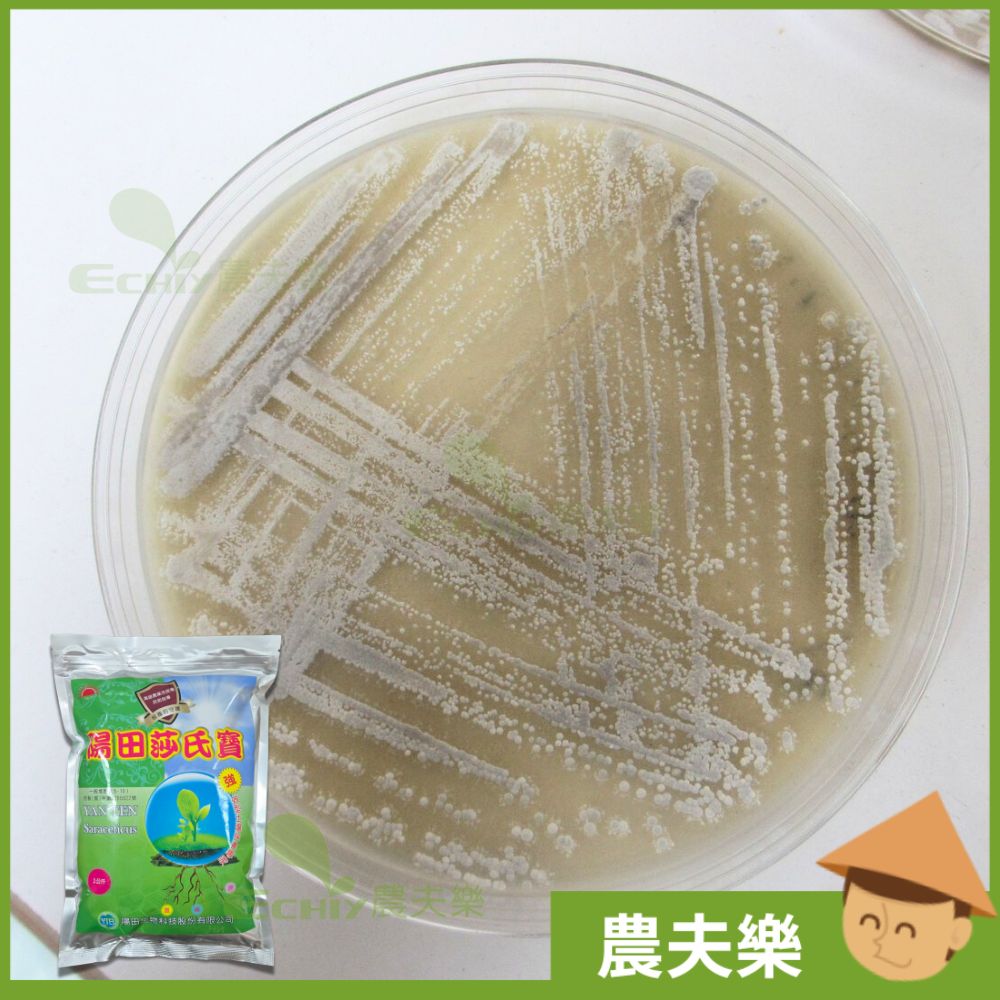

陽田莎氏寶(原莎氏菌) - 天然植物保護劑特性:
- 本產品針對土壤保養設計,內含許多特殊營養物,可吸引如放線菌類等有益微生物大量繁殖。
- 持續噴灑於土壤對植物根圈環境維護效果顯著,有效降低作物因根系受損而產生的減產情形。
產品介紹
- 土壤組成複雜,存在著有機、無機各種營養源,土壤棲息的眾多微生物裡,有些扮演重要的角色,控制有機及無機肥份釋放效率,和線蟲、病蟲害的防治,例如放線菌就是其中龐大的一屬。天然土壤環境中,微生物及植物經過數千年的演化,達到一個平衡的狀態,但這個平衡在人為的農業行為,尤其是殺菌劑、除草劑的濫用下遭到破壞,導致田間障礙越來越多。
- 根系對於植物就像動物的心臟和胃一樣,水分和營養藉由細根的吸收,再經由維管束送達全身。由此可知,根系的健康與否,對於作物的生長以及最後的產量,有絕對的影響性。良好的根圈環境營造,可以降低有害 的原生動物(如線蟲),或是其餘可能危害植物之微生物的生長,此外,亦可提高像是氮、磷、鉀等養分的吸收效率,營養充足的情況之下,根群的生長必定是非常壯碩又健康。
- 本產品由高雄農改場專業技術指導,針對土壤保養設計,內含許多特殊營養物,可吸引如放線菌類等有益微生物大量繁殖。
- 持續噴灑於土壤對植物根圈環境維護效果顯著,有效降低作物因根系受損而產生的減產情形。
- 有效提供胺基酸、維生素等綜合營養物質,幫助作物生長並增加植株強健度,提高農民整體收成。
- 本產品對蛋白質、澱粉、纖維素等分解效果極強,可搭配有機資材、廚餘,迅速製成固態或液態有機肥料,並降低發酵臭味。
- 本產品非化學藥劑,屬無毒資材,對人畜無害,適用「有機農法」。
- 1公斤裝
- 請於使用前一天先行浸泡,再將浸泡好的溶液澆灌於土壤或噴灑於葉面,適用於各類蔬菜、果樹等作物。每公斤使用200~500公升的水,視情況調整使用量。
- 可直接撒施於土壤表面,再耕犁翻入土中。
- 每分地建議用量1公斤
常溫保存有效日期:1年
| 商品名稱 | 陽田莎氏寶 | ||
|---|---|---|---|
| 登記成分 | 稻殼、米糠、蚵殼粉、甲殼質(蝦、蟹)、燕麥、麥麩、大麥。 全氮2.8%、全磷酐2.0%、全氧化鉀2.0%、有機質70.0% | ||
| 登記字號 | 製質0285022 | ||
| 品目名稱 | 5-10-一般堆肥 | ||
| 有效日期 | 請參考商品標示 | ||
| 業者名稱 | 0285-陽田生物科技股份有限公司 | ||
資訊來源:行政院農業委員會農糧署肥料管理整合資訊系統
物流說明


配送方式

- 小7:9公斤,全家:6公斤
- 包裝限制:45*30*30cm
- 便利商店僅服務註冊會員
- 配送約3~4日

- 可寄送總重量大於20公斤
- 無寄送偏遠山區及離島地區
- 偏遠地區定義:沒在你家附近出現過
- 配送約1~3日(不含例假)

- 單件重量不超過20公斤
- 包裹總長不可超過150公分
- 無寄送離島地區
- 配送約1~3日(不含例假)

- 單件重量不超過19.5公斤
- 包裹總長不可超過150公分
- 無寄送離島地區
- 可指定配送時間
- 配送約1~3日(不含例假)

- 單件重量不超過19.5公斤
- 包裹總長不可超過150公分
- 可寄送偏遠山區及離島地區
- 配送約1~3日(不含例假)

- 港、澳會員(專用物流)
- 匯款後貨到付運費
- 送時間約為7日內(不含例假)
付款與配送
| 轉帳匯款物流直送 | 貨到付款 | 網路信用卡刷卡 | |
![]() |
|||
![]() |
|||
![]() |
|||
![]() |

必看
調皮、淘氣的客人
- 吃飽飯來逛街的
- 自取"必看"沒看的
- 打破砂鍋問到底的
- 愛亂殺價的
- 臨時自取,門口狂按電鈴的
- 拿出鐵青的千元大鈔要找零的
- 隱瞞身分來探路的
- 2026目前頑皮人數:1
有閱讀自取的好康
- 幾乎不收尾數零頭
- 亂送消費者用的到產品
- 如倉庫有即期品任君免費挑一種
- 以上好康前題是前天沒跟老婆吵架
相關商品



















